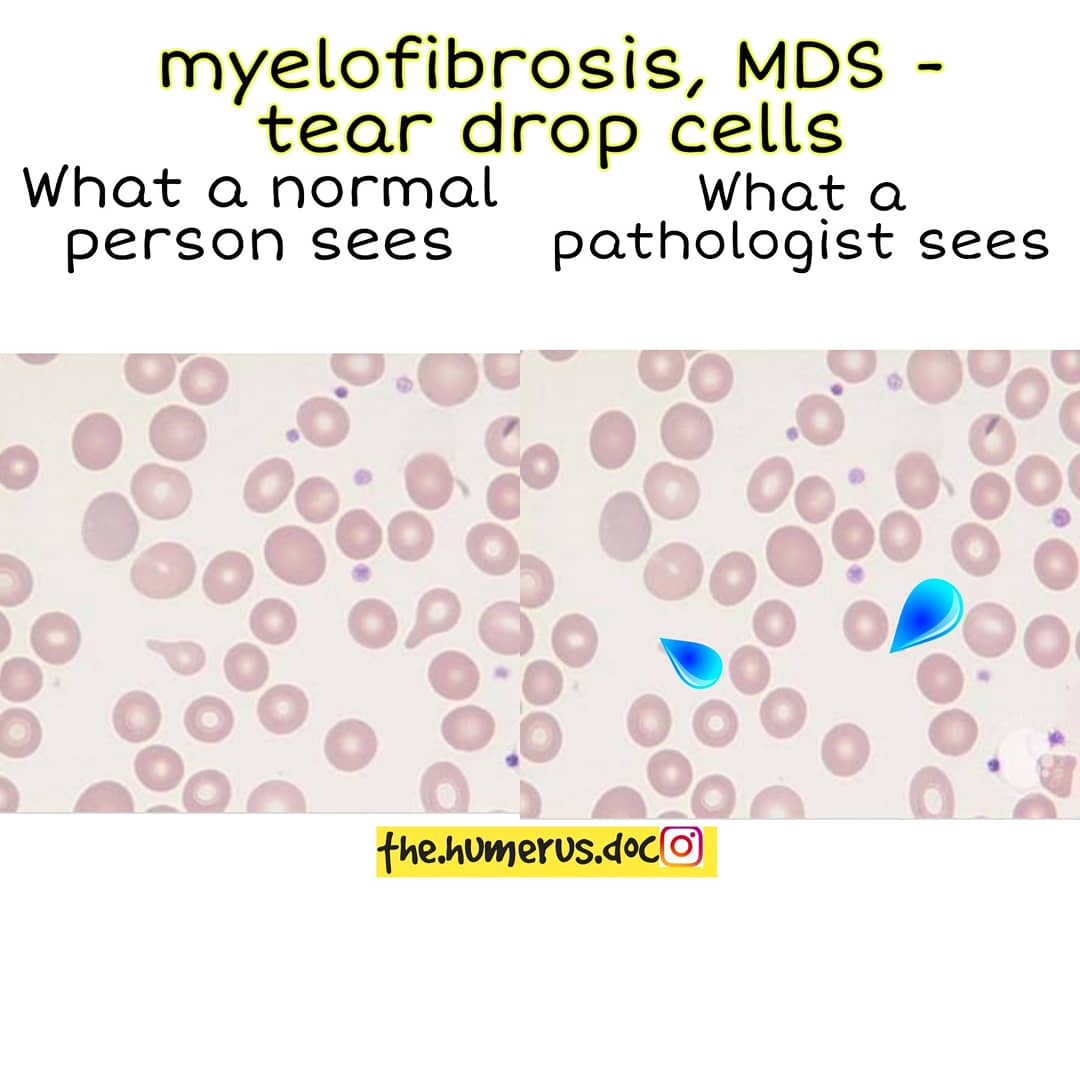
Thread on what a normal person sees vs what a pathologist sees
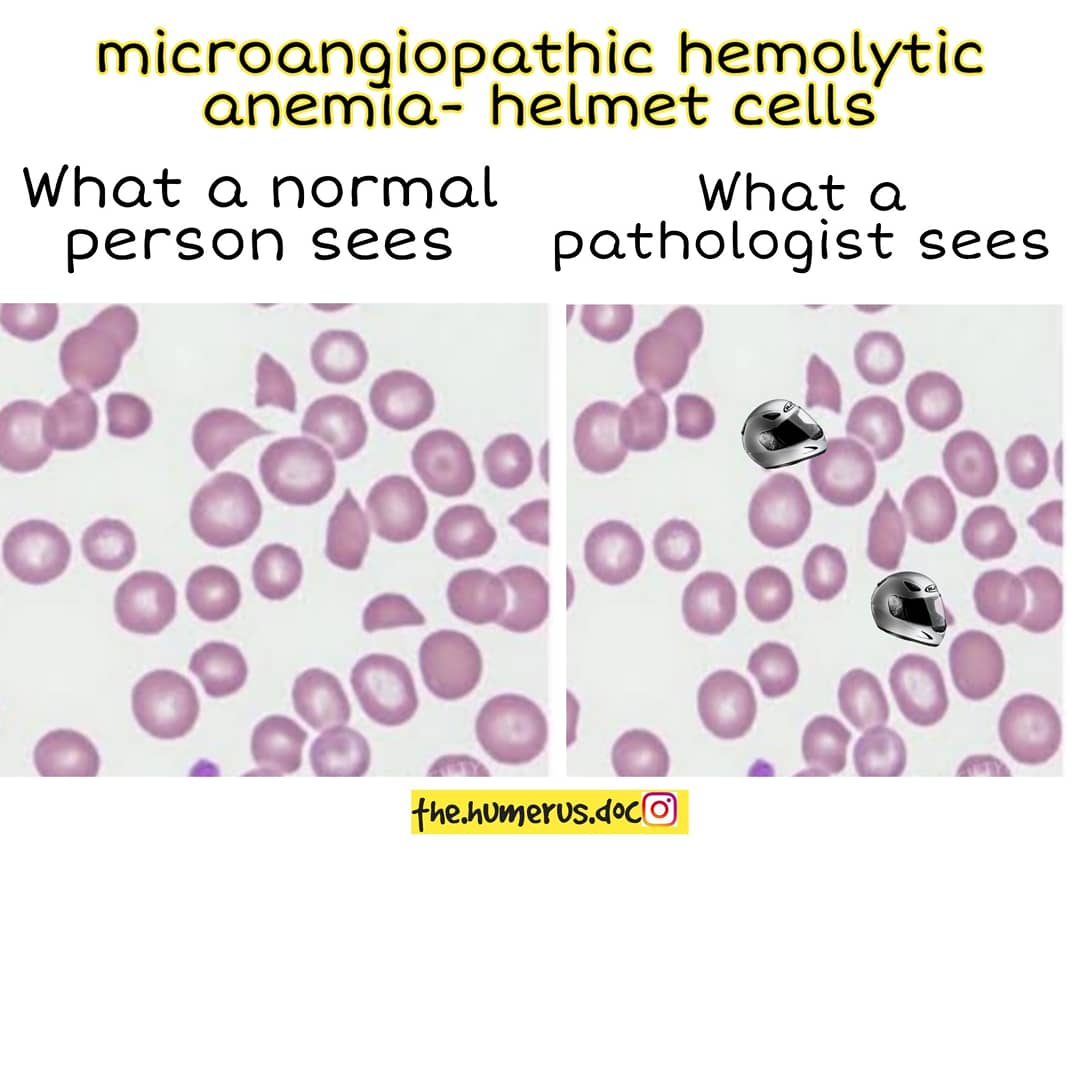
Thread on what a normal person sees vs what a pathologist sees

Thread on what a normal person sees vs what a pathologist sees
You can follow @mohdimran2000k.
Tip: mention @twtextapp on a Twitter thread with the keyword “unroll” to get a link to it.

 Read on Twitter
Read on Twitter